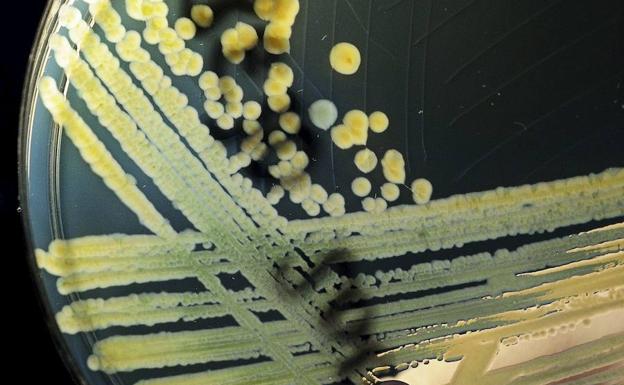
Descubren cómo las bacterias se hacen resistentes a los antibióticos

Una operación única para la hidrocefalia ofrece buenos resultados para los bebés
EUROPA PRESS | Madrid
El estudio financiado por los Institutos Nacionales de Salud asignó al azar a 100 bebés de un hospital de Uganda aquejados de esta enfermedad como resultado de una infección del sistema nervioso neonatal